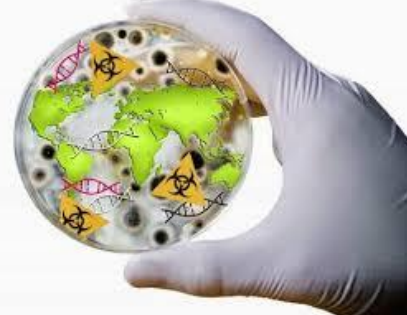

Мета навчальної дисципліни: підготовка професіонала у сфері громадського здоров’я, орієнтованого на сучасні принципи управління лабораторіями системи громадського здоров’я, в тому числі управління біологічними ризиками. Опанування дисуипліни передбачає набуття кожним здобувачем вищої освіти теоретичних знань та практичних навичок щодо основних принципів забезпечення якості результатів лабораторних досліджень, розвиток культури якості надання лабораторних послуг і формування сучасного ризик-орієнтованого способу мислення та процесного підходу до забезпечення роботи лабораторій системи громадського здоров’я.
Розробники робочої програми навчальної дисципліни: доцент закладу вищої освіти, к.мед.н., доцент Танасійчук І.С., асистент закладу вищої освіти Полушина Т.М.
Викладач: Танасійчук Ірина Сергіївна, к.мед.наук, доцент кафедри сучасних технологій медичної діагностики та лікування, національний тренер з питань впровадження системи якості лабораторних досліджень за структурованою програмою Американської спілки клінічних патологів (ASCP) та Центру контролю та профілактики захворювань США (CDC) «Підвищення кваліфікації лабораторій в напрямку до акредитації»